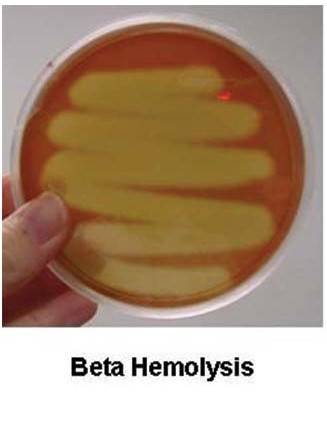
β溶血环
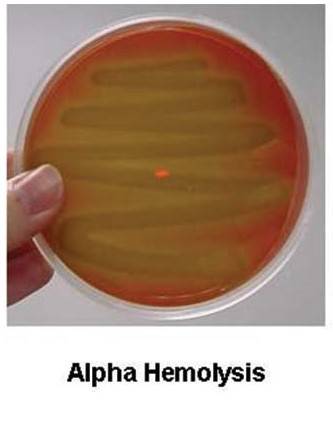
α-溶血
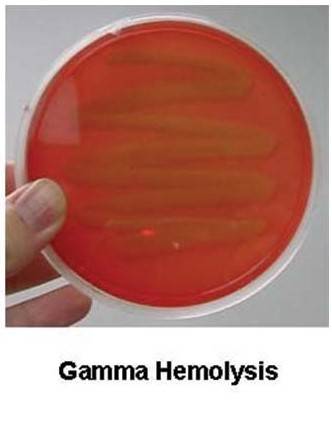
γ-溶血

溶血环:定义、类型及其在微生物学中的意义
来源:武汉市灰藻生物科技有限公司 浏览量:535 发布时间:2025-10-15 20:18:36
引言
溶血环是指在血液琼脂平板上,围绕细菌菌落出现的透明或变色的环状区域。这一现象是由于细菌分泌的溶血素,作用于培养基中的红细胞,导致其破裂或血红蛋白发生变化而产生的。
血液琼脂培养基是一种富含营养并加入了5%-10%动物(常用羊、兔或马)血液的固体培养基。
它不仅能支持细菌生长,更是一种高效的鉴别培养基。观察溶血环是初步鉴定细菌,尤其是革兰氏阳性球菌(如链球菌、葡萄球菌)的关键第一步。
这一发现可追溯至1919年,由Brown首次系统描述并定义了α、β和γ三种溶血类型。
溶血环的三种主要类型
根据溶血环的外观和其背后的溶血机制,可将其分为以下三类:
1. β-溶血(完全溶血)
• 形态特征:菌落周围出现完全透明、无色的清晰区域。光线可以毫无阻碍地穿过该区域,清晰地看到培养基的底部。这是因为红细胞被完全裂解,血红蛋白被彻底降解。
图1、β溶血环
• 发生机制:主要由细菌分泌的溶血素 所致。
例如,A群链球菌能产生溶血素O(对氧气敏感,因此在厌氧条件下活性更强)和溶血素S(对氧气稳定)。这两种毒素协同作用,破坏红细胞膜,导致完全溶血。
• 示例菌种:
• 化脓性链球菌
o 英文: Streptococcus pyogenes
o 说明: 也称为A群链球菌,是引起链球菌性咽炎、猩红热、蜂窝织炎等疾病的最典型β-溶血菌。
• 金黄色葡萄球菌
o 英文: Staphylococcus aureus
o 说明: 不仅是链球菌,许多金黄色葡萄球菌菌株也能产生强烈的β-溶血素,引起食物中毒、皮肤感染和肺炎等。
• 单核细胞增生李斯特菌
o 英文: Listeria monocytogenes
o 说明: 一种重要的食源性病原体,能在血平板上产生一个狭窄、清晰的β-溶血环,是其特征之一。
2. α-溶血(不完全/部分溶血)
• 形态特征:菌落周围出现不透明的、呈草绿色或褐绿色的晕环。该区域并非完全透明,看起来像是“褪色”或“变质”的血液。
图2、α-溶血
• 发生机制:这并非真正的红细胞裂解。细菌产生的代谢产物将红细胞内的血红蛋白氧化为高铁血红蛋白,从而导致颜色的改变。显微镜下观察,该区域的红细胞膜仍然是完整的,但内容物已发生了化学变化。
• 示例菌种:
• 肺炎链球菌
o 英文: Streptococcus pneumoniae
o 说明: 引起肺炎、脑膜炎、中耳炎的重要病原体。其α-溶血环在培养初期典型,但菌落呈“脐窝”状是其另一特点。
• 草绿色链球菌群
o 英文: Viridans Group Streptococci (VGS)
o 说明: 这不是一个菌种,而是一个群,包括:
变异链球菌: Streptococcus mutans (与龋齿相关)
血链球菌: Streptococcus sanguinis (与心内膜炎相关)
o 说明: 是口腔和上呼吸道的正常菌群,为机会性致病菌。
3. γ-溶血(非溶血)
• 形态特征:菌落周围没有任何可见的溶血环或变色区域。培养基保持原样。有时,由于细菌代谢或培养条件(如37°C、CO₂环境)可能导致培养基整体颜色略微变深,但这不属于溶血。
图3、γ-溶血
• 发生机制:该类细菌不产生任何具有临床意义的溶血素。
• 示例菌种:
• 粪肠球菌
o 英文: Enterococcus faecalis
o 说明: 过去被归类为D群链球菌,现独立成属。是肠道正常菌群,也是医院内感染(如尿路感染)的常见病原体。
• 尿肠球菌
o 英文: Enterococcus faecium
o 说明: 与粪肠球菌类似,且常表现出更强的抗生素耐药性。
• 表皮葡萄球菌
o 英文: Staphylococcus epidermidis
o 说明: 皮肤的正常菌群,通常无溶血性,是医疗器械相关感染的重要机会性致病菌。
| 溶血类型 | 中文名称 | 英文名称 | 主要特点 |
|---|---|---|---|
| β-溶血 | 化脓性链球菌 | Streptococcus pyogenes | A群链球菌,典型β-溶血 |
| 金黄色葡萄球菌 | Staphylococcus aureus | 常见病原菌,产生多种毒素 | |
| 单核细胞增生李斯特菌 | Listeria monocytogenes | 食源性病原体,窄而清晰的溶血环 | |
| α-溶血 | 肺炎链球菌 | Streptococcus pneumoniae | 菌落呈“脐窝”状,引起典型肺炎 |
| 草绿色链球菌群 | Viridans Group Streptococci | 口腔正常菌群,包括多种菌种 | |
| γ-溶血 | 粪肠球菌 | Enterococcus faecalis | 原D群链球菌,医院感染常见菌 |
| 尿肠球菌 | Enterococcus faecium | 多重耐药性常见 | |
| 表皮葡萄球菌 | Staphylococcus epidermidis | 皮肤正常菌群,生物膜形成能力强 |
溶血环存在的意义与价值
观察溶血环在临床微生物学和基础研究中具有极其重要的价值,主要体现在以下几个方面:
1. 细菌初步鉴定与分类的核心依据
• 溶血性是鉴定链球菌属和葡萄球菌属的首要特征。结合革兰氏染色(镜检观察到革兰阳性球菌成链状排列),实验室人员可以迅速将鉴定范围缩小,为后续的精确鉴定指明方向。
• 它与Lancefield血清学分群(基于细胞壁多糖抗原)相辅相成。例如,典型的A群链球菌(化脓性链球菌)是β-溶血的,而B群链球菌(无乳链球菌)则是弱β-溶血的。
2. 推断细菌致病潜力的重要线索
• 溶血素的产生往往是细菌重要的毒力因子。
o β-溶血通常与较强的侵袭性疾病相关。例如,化脓性链球菌的溶血素能直接破坏宿主细胞(不仅是红细胞,还包括白细胞和血小板),并引发强烈的炎症反应。
o α-溶血虽然看似温和,但其产生的过氧化氢等物质也能损伤组织,并帮助细菌在宿主体内(如心脏瓣膜)定植,导致亚急性或慢性感染,如感染性心内膜炎。
3. 指导临床诊断与治疗
• 快速的血琼脂平板结果可以为医生提供早期诊断信息。例如,从咽喉拭子中分离出β-溶血性链球菌,高度提示为细菌性咽炎,需使用抗生素治疗,以预防风湿热等严重并发症。
• 不同的溶血类型关联着不同的常见病原菌,这能帮助医生在获得最终药敏结果前,经验性地选择更合适的抗生素。
4. 科学研究与流行病学调查
• 在科研中,研究溶血素的基因调控、表达和功能,有助于理解细菌的致病机制,并可能成为新型抗菌药物或疫苗的靶点。
• 在流行病学调查中,通过分析特定溶血类型的菌株分布,可以追踪感染源和传播途径。
结论
总而言之,溶血环虽是一个看似简单的微生物学现象,但却是连接细菌表型、分类和致病性的关键桥梁。作为临床微生物学实验室一项经典、经济且高效的检测方法,它至今仍在细菌鉴定和感染性疾病诊断中扮演着不可或替代的重要角色。通过仔细观察菌落周围的这一圈“光环”,我们可以窥见细菌的“身份”与“攻击性”,为疾病的预防、诊断和治疗提供至关重要的第一步信息。
【相关产品】
HZB356677:化脓链球菌 | Streptococcus pyogenes
HZB364487:金黄色葡萄球菌亚种 | Staphylococcus aureus subsp.aureus
HZB355890:单核增生李斯特氏菌 | Listeria monocytogenes
HZB900173:肺炎链球菌 | Streptococcus pneumoniae
HZB358603:粪肠球菌 | Enterococcus faecalis
HZB358603:粪肠球菌 | Enterococcus faecalis
HZB356576:表皮葡萄球菌 | Staphylococcus epidermidis
敬请关注“灰藻视界”,共筑健康未来!
— 武汉市灰藻生物科技有限公司团队敬上
灰藻生物:我们期待着与客户共同成长,共创生命科学的美好未来!
更新日期:2025-10-14
编制人:小灰
审稿人:小藻
